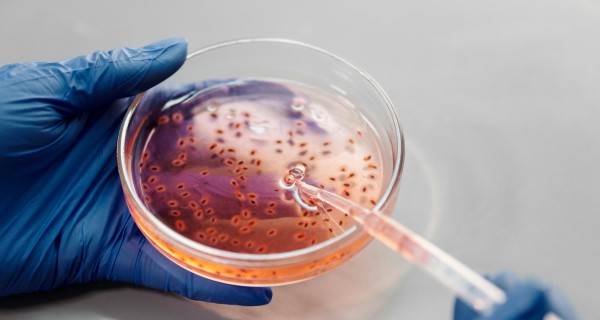

Yayınlanma Tarihi: 06 Ağustos 2025 13:32

Vibrio vulnificus, sıcak denizlerde yaşayan ve insan sağlığı için ciddi tehditler oluşturabilen bir bakteridir. Genellikle deniz ürünleri ile bağlantılı enfeksiyonların kaynağı olan bu bakteri, özellikle çiğ veya az pişirilmiş deniz ürünlerini tüketen bireylerde görünmektedir.
Et Yiyen Bakteri-Vibrio Vulnificus Nedir?
Vibrio vulnificus, sıcak denizlerde yaşayan ve insan sağlığı için ciddi tehditler oluşturabilen bir bakteridir. Genellikle deniz ürünleri ile bağlantılı enfeksiyonların kaynağı olan bu bakteri, özellikle çiğ veya az pişirilmiş deniz ürünlerini tüketen bireylerde görünmektedir. Latince ismi gibi, bu bakteri de tropik ve subtropik bölgelerde bolca bulunur. Türkiye’nin Akdeniz ve Ege kıyılarında da yaygın olarak görülebilir. Vibrio vulnificus, gnocchi, cru gibi yiyeceklerde bulunabilir ve bu nedenle deniz kumlarından bulaşabilen diğer mikroorganizmalarla birlikte büyük bir tehdit oluşturur.
Vibrio vulnificus’un İnsana Etkileri
Vibrio vulnificus, insan vücuduna girdiğinde ciddi sağlık sorunlarına yol açabilir. Özellikle sağlıklı bireylerde hafif belirtilerle geçebilirken, bağışıklık sistemi zayıf olan kişilerde oldukça tehlikeli sonuçlar doğurur. Bu bakterinin sebep olduğu enfeksiyonlar genellikle üç ana kategoride incelenir: bağırsak enfeksiyonları, yara enfeksiyonları ve kan enfeksiyonları. Bağırsak enfeksiyonları, genellikle çiğ deniz ürünlerinin tüketimi ile ilişkilidir ve karın ağrısı, ishal, bulantı gibi belirtilerle kendini gösterir. Wara enfeksiyonu, açık yaralar aracılığıyla vücuda girdiğinde, şiddetli ağrı ve iltihaplanmaya neden olabilir. Uzun süre tedavi edilmediği takdirde, bu durum sepsis gibi hayati tehlike oluşturan komplikasyonlara yol açabilir.
Belirtileri ve Tanı Yöntemleri
Vibrio vulnificus enfeksiyonunun belirtileri, enfekte olunan kişinin bağışıklık sisteminin gücüne bağlı olarak değişiklik göstermektedir. Sağlıklı bireylerde hafif gıda zehirlenmesi belirtileri, feversiz bir şekilde geçerken, bağışıklık sistemi zayıf olanlarda daha şiddetli seyrettir. Belirtiler arasında karın ağrısı, bulantı, kusma ve ishal yer alır. Yaralanmalar sonucunda ortaya çıkan yara enfeksiyonları ise, şişlik, kızarıklık, ağrı ve ulcerasyon gibi belirtilerle kendini gösterir. Kan enfeksiyonları ise, vücudun genel belirtileri dışında, titreme, ateş ve ciltte döküntü gibi belirtilerle seyreder. Teşhis koyma aşamasında, doktorlar genellikle hastaların tıbbi geçmişini, belirtilerini ve yakın zamanda tüketilen deniz ürünlerini göz önünde bulundurarak, gerekli kültür testlerini yapar.
Risk Grupları ve Öncelikli Önlemler
Vibrio vulnificus enfeksiyonuna yakalanma riski, belirli risk gruplarında daha yüksektir. Sağlık durumu zayıf olan, karaciğer hastalığı bulunan, diyabetik ve bağışıklık sistemi baskılanmış bireyler, bu bakterinin etkilerinden en fazla etkilenenlerdir. Ayrıca yaşlı bireylerde de Vibrio vulnificus’un neden olduğu sağlık sorunları oldukça tehlikeli olabilir. Bu nedenle, deniz ürünlerini tüketmeden önce kişilerin bilgi sahibi olması ve gerekli önlemleri alması oldukça önemlidir. Çiğ deniz ürünlerinden kaçınmak, deniz ürünlerini hijyenik bir şekilde pişirmek ve taze olanları tercih etmek, enfeksiyon riskini büyük ölçüde azaltmaktadır. Ayrıca, açık yaraların deniz suyuna maruz kalmaması, deniz ürünleriyle temasta bulunan kişilerin el hijyenine dikkat etmesi de menfaatlerine olacaktır.
Yazın Artan Tehlike: Sıcak Hava ve Vibrio vulnificus
Yaz aylarında, sıcak hava koşulları Vibrio vulnificus bakterisinin yayılmasını teşvik eder. Sıcak ve nemli ortamlarda, bu bakterinin üremesi hızlanır ve deniz ürünlerinin tüketimi yaygındır. Türkiye’nin kıyı bölgeleri, yaz mevsiminde deniz turizmi nedeniyle oldukça kalabalık olmaktadır. Bu durum, enfeksiyon riskini artıran bir başka faktördür. Yaz aylarında, plajlarda ve deniz kenarında daha fazla insan bulunur ve dolayısıyla daha fazla virüs veya bakteri ile temas olasılığı artar. Bu nedenle, halk sağlığına yönelik bilgilendirme çalışmaları önem kazanmaktadır.
Vibrio vulnificus ile İlgili Tedavi Yöntemleri
Vibrio vulnificus enfeksiyonları için tedavi, enfeksiyonun türüne ve hastanın genel sağlık durumuna bağlıdır. Genellikle, antibiyotik tedavisi uygulanır. Ancak, erken tanı ve tedavi durumunda daha başarılı sonuçlar elde edilmektedir. Yaraya bağlı enfeksiyonlar durumunda, yaranın temizlenmesi, drenaj yapılması ve uygun antibiyotik tedavisi uygulanması oldukça önemlidir. Enfeksiyon durumunun ilerlemesi veya sepsise dönüşmesi halinde hastaneye yatış gerektiren durumlar ortaya çıkabilir ve bu durum yaşamsal tehditler içerebilir. Bağışıklık sistemi zayıf olan bireylerin, Vibrio vulnificus enfeksiyonları açısından çok daha dikkatli olmaları gerekmektedir.
Halkı Bilinçlendirme ve Eğitim
Vibrio vulnificus ile mücadelede en önemli faktörlerden biri halkı bilinçlendirmektir. Özellikle kıyı bölgelerinde yaşayan insanlara gerekli eğitimlerin verilmesi ve sağlık kuruluşlarının bu konuda bilgilendirici kampanyalar düzenlemesi önem taşımaktadır. Bunun yanı sıra, gıda güvenliği konusunda da farkındalık oluşturmak, insanların sağlıklı deniz ürünleri tüketmelerine yardımcı olacaktır. Çiğ deniz ürünleri yerine, pişirilmiş seçeneklerin tercih edilmesi gerektiği vurgulanmalıdır.
Vibrio vulnificus sadece deniz ürünleriyle değil, aynı zamanda genel halk sağlığı ile ilgili önemli bir konudur. Türkiye’de bu bakterinin teşkil ettiği tehditlerin farkında olarak, hem bireylerin hem de sağlık kuruluşlarının daha dikkatli ve eğitimli olması gereklidir. Bunun, halk sağlığı için uzun vadede önemli yararlar sağlayacağı kesindir. Sağlık ve hijyen konusundaki bu bilinçlenme, toplumun genel sağlığı açısından büyük bir katkı sunacaktır.
Henüz yorum yapılmadı,
İlk Yorum yapan siz olun...
-
 Maden ihracatçıları da Eskişehir için THY’den tarifeli uçak sefer…
Tarkan Demir
Maden ihracatçıları da Eskişehir için THY’den tarifeli uçak sefer…
Tarkan Demir
-
 Eskişehir çok sağlıklı
Kerem Akyıl
Eskişehir çok sağlıklı
Kerem Akyıl
-
 Eskişehir örgütü Talat Yalaz'ın yanında!
Kaan Özcan
Eskişehir örgütü Talat Yalaz'ın yanında!
Kaan Özcan
-
 Tedbirli olalım
Seval Erci
Tedbirli olalım
Seval Erci
-
 Acelesi olanlara küçük bir not
Ümit Polatbaş
Acelesi olanlara küçük bir not
Ümit Polatbaş
-
 Böyle sezona başlanmaz
Ahmet D. Canoruç
Böyle sezona başlanmaz
Ahmet D. Canoruç
-
 Tepebaşı Belediyesi’nin iş birliği Eskişehirlileri ulaşımda rahat…
Funda Morgül
Tepebaşı Belediyesi’nin iş birliği Eskişehirlileri ulaşımda rahat…
Funda Morgül
-
 CHP’liler önce birbirini kazanabilirse sonra seçimleri de kazanab…
Meltem Karakaş
CHP’liler önce birbirini kazanabilirse sonra seçimleri de kazanab…
Meltem Karakaş
-
 Gürhan Albayrak ve Eskişehir İçin Yeni Bir Dönem
Rifat V. Halas
Gürhan Albayrak ve Eskişehir İçin Yeni Bir Dönem
Rifat V. Halas
-
 Sürdürülebilir kulüp kültürü
Konuk Kalem
Sürdürülebilir kulüp kültürü
Konuk Kalem
-
 2023 yılında bizi neler bekliyor?
Tülin Karagöz
2023 yılında bizi neler bekliyor?
Tülin Karagöz
-
 Düşükler neden tekrarlar?
Op. Dr. Alper Turgut
Düşükler neden tekrarlar?
Op. Dr. Alper Turgut
-
 Sağlığınız için
Uzm. Dr. Burcu Aydemir Efelerli
Sağlığınız için
Uzm. Dr. Burcu Aydemir Efelerli
-
 Vatandaşları aydınlattık
M. Murat Aslan
Vatandaşları aydınlattık
M. Murat Aslan
-
 Hayır, o yaşamak istiyor
Seda Göksoy
Hayır, o yaşamak istiyor
Seda Göksoy






























 Maden ihracatçıları da Eskişehir için THY’den tarifeli uçak sefer…
Maden ihracatçıları da Eskişehir için THY’den tarifeli uçak sefer…
 Eskişehir çok sağlıklı
Eskişehir çok sağlıklı
 Eskişehir örgütü Talat Yalaz'ın yanında!
Eskişehir örgütü Talat Yalaz'ın yanında!
 Tedbirli olalım
Tedbirli olalım
 Acelesi olanlara küçük bir not
Acelesi olanlara küçük bir not
 Böyle sezona başlanmaz
Böyle sezona başlanmaz
 Tepebaşı Belediyesi’nin iş birliği Eskişehirlileri ulaşımda rahat…
Tepebaşı Belediyesi’nin iş birliği Eskişehirlileri ulaşımda rahat…
 CHP’liler önce birbirini kazanabilirse sonra seçimleri de kazanab…
CHP’liler önce birbirini kazanabilirse sonra seçimleri de kazanab…
 2023 yılında bizi neler bekliyor?
2023 yılında bizi neler bekliyor?
 Düşükler neden tekrarlar?
Düşükler neden tekrarlar?
 Sağlığınız için
Sağlığınız için
 Vatandaşları aydınlattık
Vatandaşları aydınlattık
 Hayır, o yaşamak istiyor
Hayır, o yaşamak istiyor